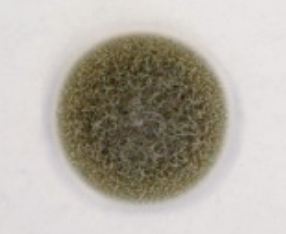
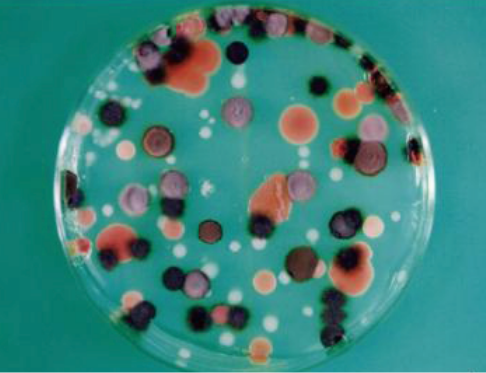

1. カビとは何か
カビに囲まれた私たちの暮らし
ショッキングに聞こえるかもしれませんが、私たちの日常生活はカビに囲まれているといっても過言ではありません。カビは目に見えなくても常に空気中や身の回りに存在しています。カビは「胞子」と呼ばれる微細な粒子を空気中に放出しています。一般的な室内空気中には、1㎥あたり数百個程度の胞子が存在しているといわれています。カビは単に存在しているだけではなく、私たちの暮らしに深く根を下ろしている存在。駆除するだけではなく、時には食生活などにも利用してきました。

カビとは何でしょう(カビの定義)
カビは細菌(バクテリア)などと同じく「微生物」とされており、生物学的には「真菌」に分類されています(カビという名称は通俗的なもの)。栄養や水分を吸収しながら菌糸を伸ばし、成熟すると胞子を形成し増殖を繰り返します。
ちなみに、カビは漢字で「黴」と書きます。かつては梅雨のことを「黴雨」と書いて「ばいう(つゆ)」と呼んでいました。じめじめとした湿気の多い時期ならではの表記といえるでしょう。
❶真菌の仲間たち
真菌はカビ以外に酵母やキノコがあり、二重膜に覆われた核と小器官を持っています。核には細胞の遺伝情報が書き込まれているDNAが内包されていて、それ以外の細胞質の部分とが核膜によって明確に区分けされています。このような構造の細胞を持つ生物は「真核生物」と分類されています。

カビと細菌との違い
同じ微生物でありながら、両者は大きな違いがあります。カビが多細胞生物でDNAが細胞核に内包される構造を持っている『真核生物』であり、細菌類は単細胞生物で細胞核を持たない『原核生物』とされています。この構造の違いが最も大きく表れるのが増殖の仕組み。細菌は単細胞生物であり、細胞自体が生きるための最小限の機能を持っているので、単純に二分裂を繰り返すだけで子孫を残すことが可能です。一方、カビはさまざまな形態や機能を持つ細胞で形成される多細胞生物で、生殖専用の細胞(胞子)によって増殖を行い、子孫を残します。種子によって増えていく植物とよく似た増殖の仕組みを持っています。
増殖のスピードは、肉眼で観察できる大きさのコロニーを生成するまで、細菌は1日程度、カビの場合は3~10日程度かかるとされています。
詳しく見る
酵母
主に単細胞の真菌で、空気中や水、土壌、植物や果物の表面など、自然界のあらゆる場所に生息しています。
酵母は糖分を分解してアルコールと炭酸ガス(二酸化炭素)を作り出す能力を持つものもおり、この性質を利用して、古くからパンや酒の製造に使われてきました。また、酵母は発酵食品(味噌、醤油、漬物など)や飲料の製造にも欠かせません(メソポタミアや古代エジプトでも利用されていた記録が残っており、5,000年以上前から利用されていたようです)。
酵母の種類は非常に多く、1,300種以上が知られていますが、食品に使われるのはごく一部に限られます。

キノコ
真菌類の一種であるキノコ。細胞壁を持ちますが、葉緑体を持たず光合成はできません。栄養は体外から吸収します。一般に「キノコ」と呼んでいる部分は「子実体」という器官で、胞子を作って散布する、植物における花や果実に相当する役目を担っています。本体は「菌糸」と呼ばれる糸状の細胞の集まりで、土壌や枯木の中で広がっています。
身近な食材であるきのこは、樹木と“共生”して栄養を互いに与え合ったり、倒木や落ち葉などを“分解”して土へと還すなど、自然界においては「森のお掃除屋さん」として重要な役割を果たしています。

閉じる
カビの構造について
カビは
●菌糸(体を構成するもので、物質を吸収する)
●胞子(カビのタネ/繁殖の単位)
という2つの要素で構成されていて、菌糸の成長と
胞子の形成というサイクルを繰り返します。
詳しく見る
菌糸
糸状の細胞で、枝分かれしながら生育します。菌糸は植物でいえば茎と根の両方の役割を兼ねており、カビ自身を支えるとともに、栄養分を吸収する役割を果たしています。この菌糸が成長し、集合したものを「菌糸体」と呼んでいます。人が目で見て「カビが生えた」と気づくのは、「菌糸体」となった状態です。
胞子
菌糸が成熟すると、先端に「胞子」と呼ばれる微細な細胞を形成します。胞子は非常に小さく、空気中に飛散し、空中を漂った胞子は新しい場所で発芽、再び菌糸体を形成します。カビの胞子は青や茶、黒色など色とりどりです。
他の微生物とのサイズ比較
細菌や真菌は非常に小さい微生物ですが、光学顕微鏡で見ることができるのに対し、ウイルスはさらに小さく、光学顕微鏡を使っても見えません。また、カビは胞子の状態では目に見えませんが、成長すると単体でも目に見えるようになります。
閉じる
カビの生活史
植物が繁殖するのと同じように、カビにも繁殖するライフサイクルがあります。カビは、胞子の発芽、菌糸の成長、胞子の形成、拡散というステップを繰り返しており、周囲の条件次第で猛烈な勢いで繁殖していきます。
❶カビの発生
カビの胞子が対象物に付着し、適切な環境が揃えば発芽し、菌糸を伸ばして成長します。
❷カビの増殖メカニズム
菌糸が成熟すると、新たな胞子を形成し、空気中を漂って拡散し、他の場所に付着して再び発芽、成長を繰り返します。
詳しく見る
胞子の発芽
カビの胞子は、湿度、温度、栄養源などの条件が揃うと、発芽して菌糸を伸ばし始めます。
菌糸の成長
発芽した胞子は、菌糸を伸ばし、枝分かれしながら周囲に網目状に生育範囲を広げます。
胞子の形成
菌糸が十分に成長すると、新たな胞子を形成します。
胞子の拡散
形成された胞子は、空気中に飛び出して、風や水、あるいは人や動物によって他の場所に運ばれ、新たな場所で発芽、成長を繰り返します。
閉じる
❸カビの生育条件
カビが発生し、生育する条件は以下の4つがあります。
詳しく見る
栄養
カビは炭水化物・タンパク質などの有機物を栄養にして成長・繁殖します。具体的には、食べ残しやホコリなどが挙げられます。中にはプラスチックを栄養源にするものもあり、私たちの身の回りにあるものには、条件さえ揃えばカビが生えてしまいます。
水分(湿度)
水分の有無や湿度の高さはカビの繁殖に大きな影響を与えるポイント。図表からもわかるとおり、湿度が60%以上の環境はカビにとって快適な湿り具合と言えます。
温度
カビが最も成長しやすい温度は、20~30℃とされており、これは人にとっても最も快適な温度帯。中には暑さや寒さを好むカビもいますが、多くのカビは人間が好む温度で最も成長します。
冬はカビにとって繁殖しづらい環境のように思えますが、近年は住まいの気密性が高まり、暖気がこもりやすいので、その他の季節と同様に室内はカビにとって好適な環境といえます。
時間
カビは、適切な温度と湿度の条件下では、胞子が対象物に付着後数日(3~10日)で目に見える大きさにまで成長します。ただ、カビの種類や栄養源、環境条件によって生育速度は大きく異なります。
上記の条件に加えて、酸素が存在する環境であればカビは繁殖を始めます。
閉じる
カビの種類
現在、カビは80,000種以上確認されていますが、今後さらに新種が発見され、種類は増加していくものと考えられています。
❶住まいの中の代表的なカビ
住まいの中で見られる代表的なカビとしてはアオカビ・コウジカビ・クロカビが挙げられることが多いようですが、このほかでよく目にするものとしては浴室の床・水栓まわりやキッチンの排水口付近などに発生するピンクぬめりがあり、これは真菌の一種である酵母が原因である場合もあります。いずれにしても、湿度・気温・栄養という繁殖のための条件がそろった場所で目にすることが多いようです。
詳しく見る
アオカビ(ペニシリウム)
食品に生えることが多いカビで、寒い所やミカンやリンゴ、餅などに生える例が知られています。また、ハウスダストにも含まれています。

コウジカビ(アスペルギルス)
パンやナッツ類、穀類などによく生えるカビ。ハウスダストの中にも含まれています。

クロカビ(クラドスポリウム)
世界で最も多いカビ。空気中に多く浮遊していて、浴室や洗面所、エアコンに黒い斑点のような姿を見せるカビ。
閉じる
カビと人間のかかわり
カビは私たちの日常に非常に近く、暮らしに大きな影響を与える存在。そこには人にとってプラスの側面とマイナスの側面があります。
❶暮らしに役立つカビ(プラスの側面)
カビの一部は、食品製造の現場で大きな役割を果たしています。特定食材の発酵過程には不可欠なほか、風味や食感、あるいは保存性を高めるという役割を担っています。また、医薬品の開発や遺伝学研究などの医療分野でも利用されています。

詳しく見る
カビを利用した食品製造
❶日本酒・味噌・醤油・みりん・塩麹・甘酒の製造
米や大豆などの原料にコウジカビ(アスペルギルス属)を繁殖させることで「麹」を作ります。この麹が分泌する酵素が原料のデンプンやタンパク質を分解、発酵を促進して独特の旨味や風味を生み出します。
❷鰹節の製造
乾燥・熟成過程でカワキコウジカビ(ユーロチウム属)を付着させます。この過程で鰹節独特の香りや旨味、保存性などが向上します。日本食の礎を築いた大発明。

カビを利用した薬品製造
❶ペニシリン(抗生物質)
アオカビ(ペニシリウム属)を利用した世界初の抗生物質で、1928年にイギリスのアレクサンダー・フレミング博士が発見。肺炎、梅毒、咽頭炎など、細菌感染症の治療に広く使用されています。

❷心血管疾患予防薬
コウジカビの一種であるアスペルギルス・テレウスは、コレステロール低下薬などの生産に利用されています。血中コレステロールを下げる薬として、心血管疾患の予防や治療に広く使用されています。
カビはこのほか、免疫抑制剤、酵素、ビタミンなど、多様な医薬品の原料や製造元として利用される一方、生物学的研究におけるモデル生物としても利活用されています。
閉じる
❷暮らしに悪影響を及ぼすカビ(マイナスの側面)
カビ(胞子)は空気中に広く存在しているため、食品に付着して増殖することで、腐敗や変色などの悪影響を及ぼします。また、住まいのさまざまな場所で繁殖し、家屋を汚すとともにその傷みにもつながりかねません。
詳しく見る
カビによって食品が腐敗・変色するメカニズム
❶付着・生育
⑴カビの胞子が食品の表面に付着します。
⑵食品の表面にカビの生育に必要な栄養・水分・酸素などの条件がそろうと、胞子から糸状の菌糸が伸びていき繁殖を始めます。
❷分解・腐敗
⑴酵素を分泌し、食品中の炭水化物・タンパク質などを分解して栄養源としつつ成長します。
⑵タンパク質が分解されるとアミノ酸になり、さらにアンモニアや硫化水素などに分解。このときに腐敗臭が発生します。
⑶でんぷんや脂質なども分解され、食品の質感や味も劣化します。
❸産生物による変色
⑴分解の際に異臭や異味を生じるほか、食品表面がぬめり、風味や食感が失われます。
⑵カビの種類によっては食品の表面に色素を出し、変色を促します。
カビによる住まいの汚染
❶美観を損ねる
カビの繁殖が進行している箇所には黒ずみなど変色した部分が現れ、美観を損う原因となります。
❷快適性の喪失
独特の異臭(カビ臭)が発生し、生活空間の快適性が失われます。特に雨漏りのたびに生えるカビとカビ臭は住人の悩みのタネ。
❸安全性・資産価値の低下
壁、床、天井など建築資材や部材の劣化・腐食を引き起こします。特に木造住宅では、柱や梁が腐食することで、家の強度や耐久性が大きく損なわれ、資産価値が下がるリスクが発生します。
生体への悪影響
カビは、空気と一緒に吸い込んだり、食べ物と一緒に口にすることで、身体に悪影響を及ぼす可能性があります。「たかがカビ」といって侮ってはいけません。
閉じる